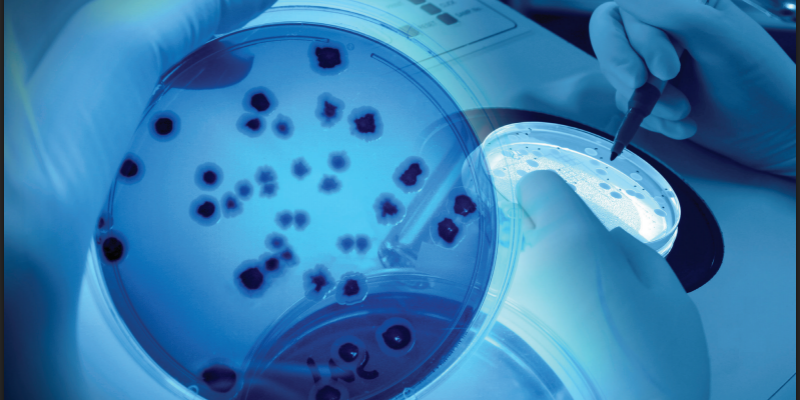
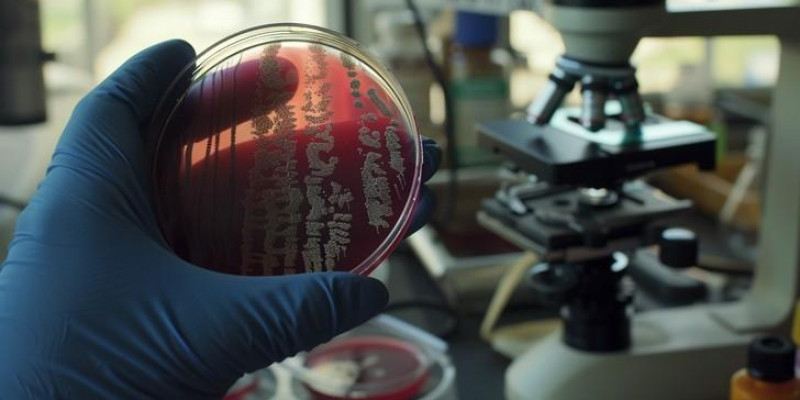

Curso Técnicas de Análise Sensorial em Alimentos
- Apresentar os princípios teóricos da análise sensorial como ciência; - Apresentar as técnicas mais comuns para avaliação sensorial de alimentos; - Discutir estudos de caso com a aplicação de técnicas sensoriais;